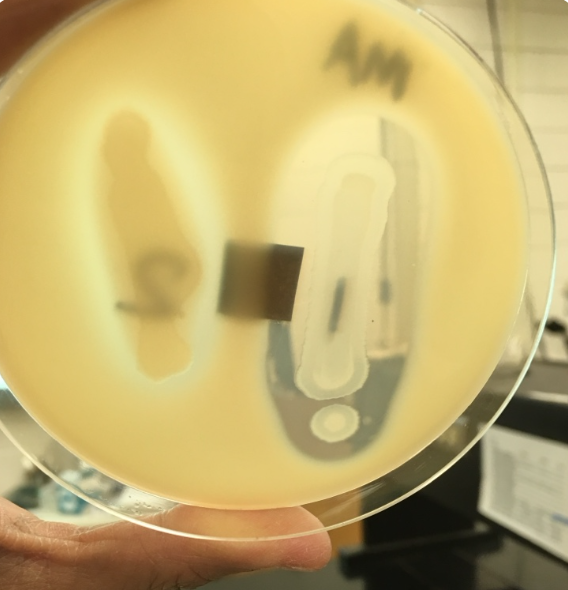
<p>A bacterium is grown on skim milk agar as shown below. The plate is opaque white, but there is a distinct, clear "halo" around the bacterial colonies around this organism on the right side indicates ________.</p><p>a. Positive for amylase.</p><p>b. Negative for gelatinase.</p><p>c. Positive for caseinase.</p><p>d. Positive for cysteine desulfhydrase.</p>
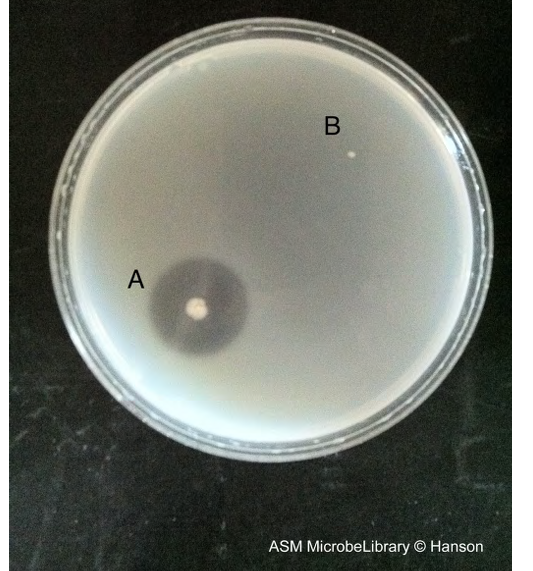
<p>In a <em>negative</em> gelatinase test (locate a pinpoint colony B), what happens when HCl is added to the plate?</p><p>a. The entire plate remains clear, including the area around the colony.</p><p>b. The plate turns brown.</p><p>c. The entire plate turns black.</p><p>d. The entire plate, including the area around the colony, turns opaque.</p>

EXAM III - BIOL 2051
1/353
Earn XP
Description and Tags
GKM 5, 6, & 7
Name | Mastery | Learn | Test | Matching | Spaced | Call with Kai |
|---|
No analytics yet
Send a link to your students to track their progress
354 Terms
"Many oxidase negative organisms are facultative aerobes capable of aerobic respiration but they use a different cytochrome to reduce oxygen." What is the most critical conclusion we can draw from this statement?
a. The oxidase assay specifically tests for cytochrome c oxidase, not all terminal oxidases.
b. Escherichia and Enterobacter are incapable of aerobic respiration.
c. A negative oxidase test proves an organism is a strict anaerobe.
d. Facultative aerobes, like E. coli, cannot produce toxic byproducts like H2O2.
a. The oxidase assay specifically tests for cytochrome c oxidase, not all terminal oxidases.
E. coli uses glycogen phosphorylase to break down its "long-term reserve energy polysaccharide." What is this polysaccharide?
a. Starch polymer of glucose connected by alpha(1 -> 4)glycosidic bonds
b. Cellulose a structural component in plant cell wall
c. Glycogen polymer of glucose alpha(1 -> 4) & (1 ->6)glycosidic bonds
d. Dextran polymer of peptides
c. Glycogen polymer of glucose alpha(1 -> 4) & (1 ->6)glycosidic bonds
Lactobacillus breaks down the organic compound lactose for both energy and carbon. It would be classified as a:
a. Photoautotroph
b. Phototroph and Heterotroph
c. Chemoorganotroph and Heterotroph
d. Chemolithotroph and Autotroph
c. Chemoorganotroph and Heterotroph
Saccharomyces is used in baking and brewing. According to the lab manual, what two products of its fermentation pathway are essential for industries?
a. Lactic acid and ethyl alcohol
b. Acetic acid (vinegar) and H2 gas
c. Lactic acid and CO2
d. CO2 and ethyl alcohol
d. CO2 and ethyl alcohol
A "chemotroph" is an organism that gets its energy from chemicals. What key information would you need to classify it as either a "chemoorganotroph" or "chemolithotroph"?
a. Whether it produces gas during fermentation.
b. Whether its carbon source is CO2 or an organic compound.
c. Whether the chemical energy source is organic or inorganic.
d. Whether it uses light for energy.
c. Whether the chemical energy source is organic or inorganic.
A "dark-dier" (dk) mutant of Chlamydomonas reinhardtii, which has a non-functional cytochrome oxidase, is grown on Sueoka's HS medium without acetate in the dark. What is the most likely outcome?
a. It will amplify their growth without the acetate in the media.
b. It will grow normally, as it can use anaerobic respiration.
c. It will fail to grow, as it cannot perform aerobic respiration.
d. It will grow normally, as photosynthesis can still occur.
c. It will fail to grow, as it cannot perform aerobic respiration.
A "zone of hydrolysis" in a starch agar test and a "clearing" in a milk agar test are both...
a. Evidence of carbohydrate fermentation.
b. Indications of H2S production.
c. False positive results caused by peptone degradation.
d. Visible evidence of extracellular enzyme activity.
d. Visible evidence of extracellular enzyme activity.
A "zone of hydrolysis" is the visible positive result for which test?
a. The amylase, caseinase and the gelatinase test
b. The Nitrate reduction and H2S production test
c. The gelatinase test
d. The fermentation test
a. The amylase, caseinase and the gelatinase test
A Streptococcus and Lactobacillus species is used fermentation of lactose (milk sugar) to produce yogurt. This organism is a __________ that primarily produces __________.
a. Yeast; alkaline products
b. Lactic acid bacterium; lactic acid
c. Lactic acid bacterium; Nitrogen gases
d. Yeast; ethyl alcohol
b. Lactic acid bacterium; lactic acid
A bacterial species is known to be a strict aerobe that relies on its ETC. If you were to analyze its enzymes, which of the following would you most expect to find as constitutive?
a. Catalase and cytochrome oxidase
b. Amylase and cellulase
c. beta-galactosidase
a. Catalase and cytochrome oxidase
A bacterium growing in a nutrient broth lacking lactose is found to have no beta-galactosidase enzyme. When lactose is added, the bacterium begins to produce the enzyme. This enzyme is best described as...?
a. A cytochrome
b. Constitutive
c. Adaptive/Inducible
d. Extracellular
c. Adaptive/Inducible
A bacterium is described as being "strictly fermentative" - that does not require oxygen and produces organic acids as end products. Which of the following test results would you expect from this organism?
a. Catalase-negative or Oxidase-negative
b. Oxidase-positive
c. Produces N2 gas from nitrate
d. Catalase-positive
a. Catalase-negative or Oxidase-negative
A bacterium is grown on skim milk agar as shown below. The plate is opaque white, but there is a distinct, clear "halo" around the bacterial colonies around this organism on the right side indicates ________.
a. Positive for amylase.
b. Negative for gelatinase.
c. Positive for caseinase.
d. Positive for cysteine desulfhydrase.
c. Positive for caseinase.

A bacterium is inoculated into a phenol red lactose broth. The result is no gas but acids formed. Which of the following tubes shows it correctly?
a. 0
b. 1
c. 2
d. 3
b. 1
A bacterium is placed on a nutrient agar plate containing starch as the only carbon source. To grow, this bacterium must produce which type of enzyme first?
a. An extracellular enzyme like amylase.
b. A constitutive endoenzyme like catalase.
c. An inducible endoenzyme like beta-galactosidase.
d. Cytochrome oxidase.
a. An extracellular enzyme like amylase.
A bacterium is plated on skim milk agar, an opaque medium because it contains the protein casein, which is a large, insoluble molecule. After incubation, the student observes good bacterial growth, but the agar remains completely white and opaque around the colonies. This means:
a. The organism did not grow on the plate.
b. The test is invalid and must be repeated with starch agar.
c. The organism is positive for caseinase.
d. The organism grew but is negative for extracellular caseinase production as no zone of hydrolysis was observed.
d. The organism grew but is negative for extracellular caseinase production as no zone of hydrolysis was observed.
A clinical microbiologist, needs to differentiate between Staphylococcus and Streptococcus. Which test is most appropriate according to the text?
a. A nitrate reduction test, as only Staphylococcus can produce N2 gas.
b. A growth test on Sueoka's media in the dark.
c. The oxidase assay, as Staphylococcus is positive and Streptococcus is negative.
d. The catalase assay, as Staphylococcus is positive and Streptococcus is negative.
d. The catalase assay, as Staphylococcus is positive and Streptococcus is negative.
A different student's tube shows no gas, no ammonia smell, and no color change after adding alpha-naphthylamine acetate and sulfanilic acid. They proceed to step 4 and add zinc powder. A red color appears after a minute. What does this result mean?
a. The bacteria are positive for nitrate reduction to nitrite.
b. The bacteria are negative for nitrate reduction (they did not use the NO3- and no bacterial nitrate reductase formed).
c. The bacteria reduced nitrate to an unknown product.
d. The bacteria are positive for denitrification.
b. The bacteria are negative for nitrate reduction (they did not use the NO3- and no bacterial nitrate reductase formed).
A lab technician performs an oxidase test on an unknown gram-negative bacterium. The test strip immediately turns a deep blue/purple. This result would be consistent with_____?
a. Neisseria, Pseudomonas, Vibrio
b. Escherichia coli
c. Enterobacter
d. Acinetobacter
a. Neisseria, Pseudomonas, Vibrio
A microorganism is grown in a carbohydrate broth with a phenol red pH indicator. The broth turns from red (uninoculated) to bright yellow, this indicates:
a. The production of neutral (alcohol) byproducts.
b. The organism could not grow.
c. The production of alkaline byproducts.
d. The production of acidic byproducts (lactic acid, succinic acid, formic acid as well as CO2) from fermentation.
d. The production of acidic byproducts (lactic acid, succinic acid, formic acid as well as CO2) from fermentation.
A mutation that destroys the function of the Fe/S (Iron-sulfur clusters) protein in Figure 9-A (CHECK LAB MANUAL) would most immediately block the transfer of electrons between______________?
a. Q and Cyt b556
b. NADH and Fp
c. Fp and Q
d. Cyt O and O2
c. Fp and Q
A new bacterium is isolated. It grows well on high salt acetate media in the dark and tests positive for catalase. Based only on this information, the organism is _______.
a. Capable of aerobic respiration.
b. A photosynthetic, oxidase-negative organism.
c. An aerobe, likely Staphylococcus.
d. Capable of denitrification.
a. Capable of aerobic respiration.
A positive test for cysteine desulfhydrase in a Peptone Iron Agar *deeps, is indicated by:
a. Ferric citrate (H₂S indicator), reacted with the H₂S gas to form a black visible precipitate of ferrous sulfide (FeS).
b. The media turning opaque after the addition of HCl.
c. A "rotten egg odor," as H2S gas is trapped in the Durham tube.
d. A clear zone around the colony.
a. Ferric citrate (H₂S indicator), reacted with the H₂S gas to form a black visible precipitate of ferrous sulfide (FeS).
A researcher floods a starch agar plate with iodine. They observe a distinct, a clear zone of hydrolysis around the bacterial colony, while the rest of the plate turns dark brown. This indicates:
a. The organism is positive for cellulase, which cross-reacts with the starch.
b. The organism fermented the starch, producing acidic byproducts.
c. The organism is negative for amylase, as the iodine did not react.
d. The organism produced the enzyme amylase, which hydrolyzed the starch to maltose and glucose.
d. The organism produced the enzyme amylase, which hydrolyzed the starch to maltose and glucose.
A researcher inoculates a wild-type strain of facultative heterotroph Chlamydomonas reinhardtii onto Sueoka's high salt growth medium + acetate (HSA) and places it in complete darkness. What is the expected outcome?
a. The cells will die because photosynthesis is impossible in dark.
b. The cells will survive but not grow, as HSA medium lacks an electron source.
c. The cells will grow by performing anaerobic respiration using acetate.
d. The cells will grow by performing aerobic respiration using acetate as carbon source.
d. The cells will grow by performing aerobic respiration using acetate as carbon source.
A researcher is comparing two unknown bacteria. She first documents that one is a rod (bacillus) and the other is a sphere (coccus). She then performs an oxidase test. This researcher is studying the organisms'...?
a. Physiology only
b. Both morphology and physiology
c. Morphology only
d. Neither morphology nor physiology
b. Both morphology and physiology
A soil microorganism is found to be reducing nitrate to produce ammonia (NH3). According to the text, this organism is performing...?
a. Denitrification.
b. Aerobic respiration.
c. A form of nitrate reduction that is not denitrification.
d. A reaction catalyzed by catalase.
c. A form of nitrate reduction that is not denitrification.
A student analyzes a bacterium and finds it produces cellulase, amylase, and beta-galactosidase. These enzymes are primarily involved in_____?
a. Protecting the cell from oxidative damage.
b. The acquisition and breakdown of complex nutrients.
c. The final stages of the aerobic electron transport chain.
d. Synthesizing molecules needed inside the cell.
b. The acquisition and breakdown of complex nutrients.
A student floods a starch agar (SA) plate with iodine.
The area around the positive test organism—*B. subtilis* inoculation—is clear, while the areas around the "Sample and E. coli" inoculations both turn dark brown.
What is the correct conclusion for the "Sample"?
a. The sample is positive for amylase.
b. The test is invalid because the positive control (*B. subtilis*) failed.
c. The sample is positive for caseinase.
d. it is negative for starch hydrolysis and does not produce the amylase
d. it is negative for starch hydrolysis and does not produce the amylase
A student floods a starch agar plate with iodine. The entire plate, including the area directly adjacent to the bacterial colony, turns dark brown. This indicates:
a. The organism is fermenting the starch.
b. The organism is negative for amylase.
c. The organism is positive for caseinase.
d. The organism is positive for amylase.
b. The organism is negative for amylase.
A student has a bacterium that they suspect produces amylase. They grow it on a starch agar plate and a skim milk agar plate. To confirm their hypothesis, what single reagent should they add?
a. Iodine to the skim milk agar plate.
b. Ferric citrate to the starch agar plate.
c. Hydrochloric acid (HCl) to the starch agar plate.
d. Iodine to the starch agar plate.
d. Iodine to the starch agar plate.
A student has an unknown "Sample" that is positive on Milk Agar (clear zone) and negative on Starch Agar (brown color with iodine). This organism produces:
a. Neither amylase nor caseinase.
b. Caseinase but not amylase.
c. Amylase but not caseinase.
d. Both amylase and caseinase.
b. Caseinase but not amylase.
A student has one of each of the three test plates (SA, MA, GA) inoculated with Bacillus subtilis. To read all three plates correctly on Day 2, what reagents are required?
a. Iodine for SA, HCl for GA, and no reagent for MA.
b. HCl for SA, Iodine for GA, and no reagent for MA.
c. Iodine for all three plates.
d. HCl for all three plates.
a. Iodine for SA, HCl for GA, and no reagent for MA.
A student inoculates a nitrate broth tube, which includes a submerged Durham tube. After 48 hours, they observe a large gas bubble in the Durham tube. What is the correct conclusion and the next step?
a. The tube is uninterpretable; they must add zinc to confirm.
b. The bacteria performed denitrification; the test is complete and positive for N2O or N2.
c. The bacteria reduced nitrate to ammonia; they should now smell the tube.
d. The bacteria are fermenting; they should now add reagents A and B.
b. The bacteria performed denitrification; the test is complete and positive for N2O or N2.
A student inoculates a Peptone Iron Agar deep with their "Sample." After incubation, the entire tube, including the area along the stab line, is still the original, uncolored media. This result means the sample is:
a. An invalid test; the tube should have turned black or clear.
b. Positive for caseinase.
c. Negative for H2S production.
d. Positive for H2S production.
c. Negative for H2S production.
A student inoculates a Peptone Iron Agar deep. After incubation, the tube is entirely black. What enzyme is present?
a. Caseinase
b. Cysteine desulfhydrase
c. Amylase
d. Gelatinase
b. Cysteine desulfhydrase

A student inoculates a phenol red glucose broth. After incubation, the tube is bright pink and cloudy. What is the most accurate physiological interpretation of this result?
a. The organism fermented glucose and produced alkaline byproducts.
b. The organism did not ferment glucose; it grew by catabolizing peptones, producing alkaline byproducts.
c. The organism failed to grow in the broth.
d. The organism fermented glucose and produced neutral byproducts, like alcohol.
b. The organism did not ferment glucose; it grew by catabolizing peptones, producing alkaline byproducts.
A student inoculates a phenol red lactose broth with an unknown bacterium. After incubation, the broth is bright pink and cloudy. What is the correct metabolic interpretation?
a. The bacterium did not grow, and the media turned pink spontaneously.
b. The bacterium fermented lactose, but the acid was neutralized by the peptones.
c. The bacterium could not ferment lactose, so it degraded peptones, producing alkaline byproducts.
d. The bacterium fermented lactose, producing alkaline byproducts.
c. The bacterium could not ferment lactose, so it degraded peptones, producing alkaline byproducts.
A student is analyzing an nitrate broth tube inoculated with Paracoccus denitrificans. What is the correct sequence of tests they should perform after incubation?
a. Add Zinc -> Add a-naphthylamine acetate + sulfanilic acid -> Check for gas -> Smell for ammonia> red color formed
b. Check for gas (Durham) -> Smell for ammonia -> Add a-naphthylamine acetate + sulfanilic acid -> Add Zinc >>> red color not formed
c. Smell for ammonia -> Add a-naphthylamine acetate + sulfanilic acid -> Check for gas -> Add Zinc
d. Add a-naphthylamine acetate + sulfanilic acid -> Add Zinc -> Smell for ammonia -> Check for gas >> blue color formed
b. Check for gas (Durham) -> Smell for ammonia -> Add a-naphthylamine acetate + sulfanilic acid -> Add Zinc >>> red color not formed
A student is given a bacterium and told it is a "chemolithotroph." What does this mean?
a. It uses light as an energy source.
b. It uses CO2 as its carbon source.
c. It uses organic compounds as an energy source.
d. It uses inorganic compounds as an energy source.
d. It uses inorganic compounds as an energy source.

A student observes a phenol red mannitol broth with Staphylococcus aureus sps. that is yellow and cloudy (like in tube a), with a large gas bubble floating at the top of the inverted Durham tube. How would this be recorded in Table 9-6?
a. Growth: Y, Acid: N, Gas: N
b. Growth: Y, Acid: N, Gas: Y
c. Growth: N, Acid: Y, Gas: Y
d. Growth: Y, Acid: Y, Gas: Y
d. Growth: Y, Acid: Y, Gas: Y
A student observes their Milk Agar (MA) plate as you did in Lab. There is a clear "halo" around the B. subtilis growth, but the agar remains opaque-white under and around E. coli and the "Sample". What does it mean about the "sample":
a. The sample is positive for amylase, which cross-reacts on milk agar.
b. The test is invalid, as the E. coli (negative control) should have a clear zone.
c. The sample is negative for caseinase, and the test is valid.
d. The sample is positive for caseinase.
c. The sample is negative for caseinase, and the test is valid.
A student tests a bacterial colony for catalase by adding a drop of hydrogen peroxide. Vigorous bubbling is observed. This indicates the bacterium_____?
a. Is likely a fermentative organism, such as Streptococcus.
b. Is performing denitrification and releasing N2 gas.
c. Is oxidase-positive, as bubbling is the sign of a positive oxidase test.
d. Likely utilizes aerobic respiration, producing catalase to detoxify H₂O₂..
d. Likely utilizes aerobic respiration, producing catalase to detoxify H₂O₂..
A student's gelatinase (GA) plate did not show a clear zone around E. coli after adding 1N HCl. What is the most possible interpretation?
a. The E.coli culture did not produce gelatinase.
b. The gelatin melted after adding HCl.
c. The E.coli culture was viable and produced gelatinase.
d. The Bacillus subtilis contaminated the plate.
a. The E.coli culture did not produce gelatinase.
A student's phenol red glucose broth appears yellow (cloudy, no gas). The sucrose tube is orange/red (cloudy, no gas). What is the correct interpretation?
a. The organism ferments glucose (producing acid) but does not ferment sucrose (though it did grow).
b. The organism ferments both glucose and sucrose.
c. The organism did not grow in either tube.
d. The organism fermented sucrose but not glucose.
a. The organism ferments glucose (producing acid) but does not ferment sucrose (though it did grow).
A student's tube of phenol red carbohydrate broth turns bright yellow. Which of the following could have caused this pH drop?
a. The production of alkaline byproducts.
b. The organism failing to grow.
c. Production of lactic acid, formic acid, or CO2.
d. Production of peptones.
c. Production of lactic acid, formic acid, or CO2.
A student's tube shows no gas, no ammonia smell, and no color change after adding reagents—sulfanilic acid and alpha-naphthylamine. They add zinc, and still no red color appears. What is the only valid conclusion from this test?
a. The bacteria are negative for nitrate reduction.
b. The zinc was defective and failed to reduce the nitrate.
c. The bacteria did not grow in the tube.
d. The bacteria reduced the nitrate, and the products could not be determined by the subsequent tests (or non-detectable levels of nitrous oxide N2O, ammonia NH3 or Nitrogen gas escaped).
d. The bacteria reduced the nitrate, and the products could not be determined by the subsequent tests (or non-detectable levels of nitrous oxide N2O, ammonia NH3 or Nitrogen gas escaped).
According to Figure 9-5 showing possible results for phenol red fermentation broths., what is the only visual difference between an "uninoculated control" tube and a tube showing "Growth (no acid/no alkaline byproducts/no gas))"?
a. The presence of a gas bubble
b. The color (pH)
c. The turbidity (cloudiness)
d. There is no difference.
c. The turbidity (cloudiness)
According to Figure 9-E, which of the following pathways consumes NADH?
a. The Transition Step
b. Glycolysis
c. The Citric Acid Cycle
d. Fermentation
d. Fermentation
According to Figure 9-E, which pathway is the initial stage to both fermentation and cellular respiration?
a. The Electron Transport System
b. The Transition Step (Pyruvate to Acetyl CoA)
c. The Citric Acid Cycle
d. Glycolysis
d. Glycolysis
According to the denitrification pathway shown in lab manual, which enzyme catalyzes the production of dinitrogen gas (N2) as the final step?
a. Nitric oxide reductase
b. Nitrite reductase
c. Nitrate reductase
d. Nitrous oxide reductase
d. Nitrous oxide reductase
According to the lab manual, a "fermentative organism" like Lactobacillus relies primarily on which mechanism for ATP production?
a. The Citric Acid Cycle
b. Substrate-level phosphorylation during glycolysis.
c. Photophosphorylation - uses light energy to produce ATP
d. The Electron Transport System that occur in a few strains
b. Substrate-level phosphorylation during glycolysis.
According to the Lab manual, an organism that "fixes carbon from carbon dioxide" to be used as its carbon source is called a(n):
a. Chemolithotroph
b. Heterotroph
c. Autotroph
d. Chemotroph
c. Autotroph
According to the lab-manual, the production of "various acids... as well as carbon dioxide" can cause what change in a phenol red carbohydrate broth?
a. The pH stays neutral, and the broth becomes cloudy.
b. The pH drops, but the color remains orange-red.
c. The pH rises above 8.2, and the broth turns pink.
d. The pH drops below 6.8, and the broth turns yellow.
d. The pH drops below 6.8, and the broth turns yellow.
According to the lab-manual, what is the key structural difference between starch and cellulose?
a. Starch is linked by alpha(1->4) glycosidic bonds, while cellulose is linked by beta(1->4) glycosidic bonds.
b. Starch is a structural component, while cellulose is an energy reserve.
c. Starch is made of amino acids, while cellulose is made of glucose.
d. Starch is a monosaccharide, while cellulose is a polysaccharide.
a. Starch is linked by alpha(1->4) glycosidic bonds, while cellulose is linked by beta(1->4) glycosidic bonds.
An objective listed is to "Understand the metabolic consequences of not able to produce cytochrome oxidase due to a mutation in *Chlamydomonas reinhardtii."
What is the most likely consequence?
a. The organism will be unable to use molecular oxygen as the last electron acceptor.
b. The organism will switch to using extracellular enzymes for all energy production.
c. The organism's H+ gradient will become too strong, stopping ATP production.
d. The organism will produce an excess of catalase to compensate.
a. The organism will be unable to use molecular oxygen as the last electron acceptor.
An organism is a facultative anaerobe. In an environment lacking O2 but containing nitrate (NO3-), which enzyme system would it most likely induce?
a. Cytochrome c oxidase
b. Photosynthesis
c. Nitrate reductase
d. Catalase
c. Nitrate reductase
An organism that obtains its carbon from organic compounds and its energy from the oxidation of those same organic compounds is best described as a:
a. Chemolithotroph - uses inorganic compounds as energy source
b. Autotroph - fix carbon from CO2 into methane/acetate/sugars
c. Chemoorganotroph - uses organic compounds as energy source
d. Phototroph - use light as energy source
c. Chemoorganotroph - uses organic compounds as energy source
An organism that uses light for energy and CO2 for carbon would be a:
a. Photoautotroph
b. Chemolithotroph
c. Photoheterotroph
d. Chemoorganotroph
a. Photoautotroph
Bacillus subtilis is positive for both amylase test and the caseinase test, what does it demonstrate?
a. The organism's production of an extracellular hydrolytic enzyme.
b. The organism's ability to grow in an alkaline environment.
c. The organism's ability to ferment a specific carbohydrate.
d. The organism's production of hydrogen sulfide.
a. The organism's production of an extracellular hydrolytic enzyme.
Based on Figure 9-E depicting catabolism pathway where glucose converts to pyruvate, what is the primary metabolic function of the fermentation pathway?
a. To convert pyruvate into Acetyl CoA for entry into the Citric Acid Cycle.
b. To generate a large amount of ATP through the electron transport system.
c. To reduce pyruvate, thereby oxidizing NADH back to NAD+ so glycolysis can continue.
d. To fully oxidize glucose and release CO2.
c. To reduce pyruvate, thereby oxidizing NADH back to NAD+ so glycolysis can continue.
Based on Figure 9-G showing - substrate specificity of cellulase and amylase. What is the most fundamental principle being illustrated?
a. These hydrolytic enzymes demonstrate a high degree of substrate specificity.
b. Cellulose can be broken by amylase.
c. Amylase and cellulase are both hydrolytic enzymes that can hydrolyze any polysaccharides.
d. All bacteria that produce cellulase can hydrolyze glycogen.
a. These hydrolytic enzymes demonstrate a high degree of substrate specificity.
Based on the catabolism summary in Figure 9-E, which process generates the most NADH and FADH2 for use by the Electron Transport System?
a. Glycolysis
b. Fermentation
c. The Transition Anaerobic Step
d. The Citric Acid Cycle
d. The Citric Acid Cycle
Based on the provided diagrams (Figure 9-B), what is the hierarchical relationship between the toxic byproducts of O2 reduction?
a. Hydroxyl radicals (OH•) are the starting substrate for the production of superoxide.
b. All three byproducts (O2-, H2O2, OH•) are produced independently and do not interconvert.
c. Superoxide (O2-) is reduced to form hydrogen peroxide (H2O2), which can then form a hydroxyl radical (OH•).
d. Catalase detoxifies superoxide (O2-) directly.
c. Superoxide (O2-) is reduced to form hydrogen peroxide (H2O2), which can then form a hydroxyl radical (OH•).
Chymosin, used in cheesemaking, is given as an example of which type of enzyme?
a. Caseinase (a protease)
b. Glycogen phosphorylase
c. Cellulase
d. Amylase
a. Caseinase (a protease)
Cysteine and methionine are the two amino acids mentioned that contain which element in their R-group side chains?
a. Iron
b. Iodine
c. Sulfur
d. Nitrogen
c. Sulfur
Denitrification "may result in the depletion of nitrogen from the soil."
Why is this a problem?
a. It fixes N2 gas into ammonia, which is toxic to plant roots.
b. It produces acidic byproducts that lower the soil pH.
c. It converts usable solid nitrate (NO3-) into atmospheric N2 gas, which most plants cannot use.
d. It uses up all the oxygen in the soil, suffocating plant roots.
c. It converts usable solid nitrate (NO3-) into atmospheric N2 gas, which most plants cannot use.
If a unknown bacteria can breakdown the inorganic compound nitrate for both energy and Nitrogen gas formation. Based on this information, it would be classified as a:
a. Photoautotroph
b. Autotroph
c. Phototroph and Heterotroph
d. Chemolithotroph and Heterotroph
d. Chemolithotroph and Heterotroph
In a negative gelatinase test (locate a pinpoint colony B), what happens when HCl is added to the plate?
a. The entire plate remains clear, including the area around the colony.
b. The plate turns brown.
c. The entire plate turns black.
d. The entire plate, including the area around the colony, turns opaque.
d. The entire plate, including the area around the colony, turns opaque.
In a negative gelatinase test, what is the expected observation after adding 1 N HCl?
a. The entire plate will remain clear.
b. The plate will develop a black precipitate.
c. The entire plate, including the inoculated areas, will become opaque-white.
d. The plate will turn dark brown.
c. The entire plate, including the inoculated areas, will become opaque-white.
In a positive amylase test, a "zone of hydrolysis" (clear area) is seen because:
a. The amylase has degraded the starch, so there is no starch left to react with the iodine.
b. The starch has precipitated the iodine.
c. The iodine has been hydrolyzed by the amylase.
d. The amylase has reacted with the iodine to form a clear compound.
a. The amylase has degraded the starch, so there is no starch left to react with the iodine.
In a Peptone Iron Agar deep (contain peptone and ferric citrate), what is the role of the peptone?
a. It is the gelling agent that traps the insoluble H2S gas.
b. It is the H₂S indicator, reacting with the H₂S gas to form a black visible precipitate of ferrous sulfide (FeS).
c. It is the pH indicator.
d. It is a animal digest protein source rich in the substrate, cysteine to demostrate production of hydrogen sulfide.
d. It is a animal digest protein source rich in the substrate, cysteine to demostrate production of hydrogen sulfide.
In a Peptone Iron Agar deep, what is the specific role of the ferric citrate?
a. It is the gelling agent that keeps the medium solid.
b. It is the indicator that reacts with H2S to form a black precipitate.
c. It is the substrate that is broken down by cysteine desulfhydrase.
d. It is the primary nutrient source for the bacteria.
b. It is the indicator that reacts with H2S to form a black precipitate.
In Figure 9-A, protons (H+) are shown being released into the periplasm from multiple sites. What is the source of these protons?
a. They are a direct byproduct of water (H2O) splitting.
b. They are pumped from the cytoplasm and generated from the oxidation of NADH and QH2 (ubiquinol).
c. They are brought in from outside the cell by the Fp complex.
d. They are released by molecular oxygen (O2) as it is oxidized.
b. They are pumped from the cytoplasm and generated from the oxidation of NADH and QH2 (ubiquinol).
In Figure 9-A, which component acts as a mobile electron carrier that shuttles electrons between the first and second major complexes?
a. Cyt b556 (Cytochrome b556)
b. Fe/S (Iron-sulfur clusters)
c. Q / QH2 (Coenzyme Q or Ubiquinone)
d. Fp (flavoprotein)
c. Q / QH2 (Coenzyme Q or Ubiquinone)
In Figure 9-D from lab manual, the conversion of the "Reduced oxidase reagent" to the "Oxidized oxidase reagent" is an example of____?
a. The final step of anaerobic respiration.
b. A detoxification reaction catalyzed by catalase.
c. An oxidation reaction, where the reagent loses an electron.
d. A reduction reaction, where the reagent gains an electron.
c. An oxidation reaction, where the reagent loses an electron.
In Figure 9-E in Summary of catabolism, what is the fate of the 2 NADH molecules produced during glycolysis in an organism undergoing only fermentation?
a. They are used to reduce pyruvate into fermentation end products.
b. They are used in the Citric Acid Cycle to produce FADH2.
c. They are excreted from the cell as a waste product.
d. They are used by the Electron Transport System to make ATP.
a. They are used to reduce pyruvate into fermentation end products.
In Figure 9-E the flowchart showing catabolism pathway, what is the primary metabolic fate of NADH produced during glycolysis in an organism undergoing only fermentation?
a. It is excreted from the cell as a waste product.
b. It is converted to FADH2 for use in the Citric Acid Cycle.
c. It is used by the Electron Transport System to generate ATP.
d. It is used to reduce pyruvate into fermentation end products (acids, alcohols, gases).
d. It is used to reduce pyruvate into fermentation end products (acids, alcohols, gases).
In Figure 9-F Carbohydrate Fermentation Broths, the tube on the far right (yellow) is a result of fermentation. In Figure 9-E, what category of molecules would cause this result?
a. "Acids"
b. Acetyl CoA
c. "Alcohols"
d. "Nitrogen Gases"
a. "Acids"
In Figure 9-F showing Carbohydrate broths for fermentation test, the middle tube is fuchsia/pink, indicating alkaline products. What color was this tube before inoculation?
a. Yellow at acidic pH (due to carbohydrate fermentation).
b. Red at neutral pH (uninoculated, original color, or no reaction).
c. Bright Pink (or Magenta/Fuchsia) at alkaline pH (due to peptone deamination/protein catabolism).
d. Colorless uninoculated medium
b. Red at neutral pH (uninoculated, original color, or no reaction).
In the denitrification pathway, which enzyme catalyzes the conversion of NO2- to NO?
a. Nitrate reductase
b. N2O reductase
c. Nitrite reductase
d. Nitric oxide reductase
c. Nitrite reductase
In the E. coli ETC shown in Figure 9-A, what is the specific role of the complex labeled "CytO"?
a. It is the terminal oxidase that reduces molecular oxygen.
b. It accepts electrons from NADH to start the chain.
c. It pumps H+ from the periplasm into the cytoplasm.
d. It hydrolyzes ATP to power the proton pumps.
a. It is the terminal oxidase that reduces molecular oxygen.
In the nitrate reduction follow-up, a student adds alpha-naphthylamine acetate and sulfanilic acid to their tube (which had no gas bubble). It immediately turns bright red. This indicates:
a. The bacteria reduced nitrate to nitrite (NO2-).
b. The bacteria did not reduce nitrate; nitrate (NO3-) is still present.
c. The bacteria reduced nitrate to ammonia (NH3).
d. The bacteria reduced nitrate all the way to N2 gas.
a. The bacteria reduced nitrate to nitrite (NO2-).
Proteins as macromolecules composed of one or more polypeptides. What covalent bond joins the amino acids in these chains?
a. Peptide bonds
b. Glycosidic bonds
c. Disulfide linkages
d. Carbon-sulfur bonds
a. Peptide bonds
The "black insoluble precipitate" that indicates a positive H2S test is:
a. Ferrous sulfide (FeS)
b. Pyruvate
c. Hydrogen sulfide (H2S)
d. Ferric citrate
a. Ferrous sulfide (FeS)
The "dark-dier" (dk) mutants of Chlamydomonas reinhardtii, have a mutation in a mitochondrial gene for expressing cytochrome oxidase a critical enzyme in the mitochondrial electron transport chain for respiration. This location is significant because_____?
a. Denitrification enzymes are located in the mitochondria.
b. The mutation prevents acetate from entering the mitochondria.
c. Photosynthesis occurs in the mitochondria of green algae.
d. Mutation disrupts the organism's ability to perform aerobic respiration, especially in the dark.
d. Mutation disrupts the organism's ability to perform aerobic respiration, especially in the dark.
The "Practical Uses" for chymosin a caseinase used in cheesemaking. This is an example of a:
a. Carbohydrate
b. Protease
c. Amylase
d. Cysteine desulfhydrase
b. Protease
The "Practical Uses" highlights that catalase and cytochrome c oxidase tests are used to________?
a. Differentiate between different bacterial genera.
b. Measure the rate of ATP synthesis in a cell.
c. Determine the morphology of microorganisms.
d. Identify whether an enzyme is inducible or constitutive.
a. Differentiate between different bacterial genera.
The enzyme cysteine desulfhydrase (EC 4.4.1.15) is also described as a:
a. Carbon-sulfur lyase
b. Caseinase
c. Protease
d. Amylase
a. Carbon-sulfur lyase
The ETC is a "series of redox reactions." In the context of Figure 9-A, which component is in its reduced state when it is labeled QH2?
a. Cyt O
b. 1/2 O2
c. Q
d. Fp
c. Q
The lab manual states that "fermentative organisms rely upon substrate-level phosphorylation to produce a reduced organic compound." What is the actual source of ATP for these organisms?
a. The Citric Acid Cycle, which is powered by the reduced organic compound.
b. The Electron Transport System, which is powered by the reduced organic compound.
c. The text is correct; the reduced organic compound is the ATP.
d. Glycolysis, which produces a small amount of ATP via substrate-level phosphorylation.
d. Glycolysis, which produces a small amount of ATP via substrate-level phosphorylation.
The lab-manual states that "oxidase and catalase enzymes are made by organisms that produce energy using aerobic respiration." This implies that______?
a. These enzymes are only produced when O2 is absent.
b. All organisms that produce catalase are strict aerobes.
c. A strict anaerobe would likely test negative for these specific enzymes.
d. These enzymes are responsible for anaerobic respiration.
c. A strict anaerobe would likely test negative for these specific enzymes
The production of inducible enzymes like beta-galactosidase as an "energy-conserving mechanism." Why?
a. It ensures the enzyme is only synthesized when its specific substrate is available, preventing wasteful protein production.
b. It allows the cell to produce ATP at a much faster rate than constitutive enzymes.
c. It is an extracellular enzyme that functions without using any cellular ATP.
d. It breaks down complex sugars (like lactose) into simpler ones (like glucose) which release more energy.
a. It ensures the enzyme is only synthesized when its specific substrate is available, preventing wasteful protein production.
The production of yogurt by Streptococcus and the production of wine by Saccharomyces are both examples of:
a. Industrial uses of chemolithotrophs.
b. Catabolism of peptones to produce alkaline products like ammonia.
c. Using enzymes like caseinase that hydrolyzes the milk protein.
d. Practical uses of microbial fermentation by chemoorganotroph.
d. Practical uses of microbial fermentation by chemoorganotroph.
What are the three products of the reaction catalyzed by cysteine desulfhydrase produced by Citrobacter freundii?
a. Pyruvate, Ferrous Sulfide (FeS), and Water
b. Cysteine, Ammonia, and Pyruvate
c. Water, Cysteine, and H2S
d. Ammonia, Pyruvate, and Hydrogen Sulfide (H2S)
d. Ammonia, Pyruvate, and Hydrogen Sulfide (H2S)
What are the two reagents used to test for the presence of nitrite (NO2-)?
a. alpha-naphthylamine acetate and sulfanilic acid
b. Durham tubes and alpha-naphthylamine acetate
c. Zinc powder and sulfanilic acid
d. alpha-naphthylamine acetate and zinc powder
a. alpha-naphthylamine acetate and sulfanilic acid
What do amylase, gelatinase, and caseinase have in common?
a. They all ferment carbohydrates to produce acidic byproducts.
b. They are all hydrolytic enzymes that break down specific large biomolecules.
c. They are all used to detect hydrogen sulfide production.
d. They are all endoenzymes involved in the Citric Acid Cycle.
b. They are all hydrolytic enzymes that break down specific large biomolecules.
What is the "practical use" of identifying a microorganism's ability to use nitrate as an electron acceptor under anaerobic condition?
a. It aids in the physiological identification of the microorganism.
b. It indicates whether the organism will be catalase-positive.
c. It confirms the organism is a strict aerobe.
d. It helps determine if the organism is photosynthetic.
a. It aids in the physiological identification of the microorganism.
What is the correct inoculation method for the Peptone Iron Agar deep?
a. Stabbing the medium 1-2 cm deep with an inoculating needle.
b. Pouring a broth culture into the deep.
c. Flooding the surface with iodine.
d. Streaking the surface with an inoculating loop.
a. Stabbing the medium 1-2 cm deep with an inoculating needle.
What is the correct metabolic sequence for a bacterium to utilize a large extracellular protein like casein?
a. Amino Acids -> Transport -> Build Peptides -> Build Protease
b. Transport (Casein) -> Protease -> Peptides -> Amino Acids
c. Protease -> Transport (Peptides) -> Degrade to Amino Acids (in cytoplasm)
d. Protease (e.g., Caseinase) -> Peptides -> Degrade to Amino Acids -> Transport (Amino Acids)
d. Protease (e.g., Caseinase) -> Peptides -> Degrade to Amino Acids -> Transport (Amino Acids)